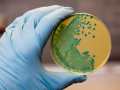

限时免费开放200个「100000+Foodaily食品创新交流群」进群名额,分享前沿行业资讯|优质上下游资源
扫码添加官方企微回复“进群”,名额有限!
新消息
在CAGNY(消费者分析师集团研讨会,Consumer Analyst Group of New York Conference)上,通用磨坊尝试说服投资者对其重振销售业绩的计划保持信心由于在美国的酸奶业务和汤罐头业务表现不如预期,上周通用磨坊降低了本
foodaily
2017.05.08
2018年,CDC(美国疾病控制与预防中心)将开始使用全基因组测序来鉴定沙门氏菌、弯曲杆菌和大肠杆菌等病原体在最近召开的全球食品安全会议上,关于行业协作、学术界及监管机构的小组讨论本来可能会解决李斯特菌的控制
foodaily
2017.05.08
siratose在罗汉果中微量存在,Senomyx计划通过发酵实现批量生产Senomyx已经发现了一种新型零卡路里、高效的甜味剂,微量存在于罗汉果中,计划通过发酵实现商业化生产。这种甜味剂在食品标签上被称为siratose,自称远
foodaily
2017.05.08
HowGood 想要精简商店中普遍存在的食品和饮料包装上杂乱的标签和认证。对品牌和制造商来说,根本不需要重新设计包装或进行额外的认证。相反,等级评定使产品在商店中更具特色,最标准的形式是一个印有产品价格的标签
foodaily
2017.05.07
通过开发营养食品,日本乳业巨头Morinaga(森永乳业)将在Anaheim(阿纳海姆)西部食品博览会上展出ALOVE芦荟酸奶,并以此为契机进军美国乳品市场。首先由希腊进入美国乳品市场,其次是冰岛。这次日本会取得成功吗?
foodaily
2017.05.07
这个年头,总能听到某某公司开发昆虫食品计划。与这些虫虫项目相比,来自丹麦Insekt KBH公司的苹果-姜-蟋蟀果汁的确有些与众不同:它的可持续发展不仅是依靠其巧妙独特的原料搭配,还因为它属于哥本哈根自给自足的城
foodaily
2017.05.07
Sweet Green Fields公司首席科学家Mel Jackson博士近日接受记者采访,谈到甜菊糖的发展时说道:如果说高纯度Reb A曾是甜叶菊在甜味剂领域唯一的明星产品,那么在过去的几年里,随着诸多供应商竞相提供满足消费者需求
foodaily
2017.05.05
好时公司近日公布了一项为期三年的利润增长计划,通过优化供应链、精简经营模式以及降低企业管理费用来提高利润率。该计划旨在为品牌和能力的持续投资提供灵活性和动力,从而有助于实现远期愿景。糖果和零食业务的增
foodaily
2017.05.05
用剩余蔬菜制成的鹰嘴豆酱,含有超级食物的咖喱式洛依柏丝茶和无麸质面条,获得了由威廉里德商业媒体(William Reed Business Media)主办的Food Vision 2017创新产品奖。三家初创企业的创始人亮相于2月底在伦敦举行
foodaily
2017.05.05
通过大量调查研究,我们确定了未来将影响日本食品市场走向的六大食品和营养消费趋势。这些趋势涵盖了从超级食品到运动营养品等各个方面。1、人口出生率降低,且老龄化问题严重日本的人口数量多年来一直在减少,且没有
2017.05.05
Cmoi在法国推出可控发酵工艺生产的可可及其巧克力制品法国公司Cmoi近日推出自有品牌巧克力,采用由可控的可可发酵工艺产出的可可制作。产品将很快在法国主要超市上市,也会有巧克力糖衣和可可液块供应给第三方。干燥
foodaily
2017.05.04
位于瑞典马尔默的AAKAB公司首席营销官Anne Mette Olesen,与位于美国新泽西州Edison市的AAK公司总裁 Terry Thomas一起正式为美国首家AAK 研发中心揭幕位于新泽西州Edison的美国AAK公司日前建成了旗舰研发中心AAKtion
foodaily
2017.05.04
美国有机酸奶制造商Stonyfield近日对外宣布了产品减糖计划。经过两年多的研究,Stonyfield利用其庞大的菌种库,获得能降低酸度,平衡酸奶甜度的配方,这样可以在味道不打折的基础上实现降糖。Stonyfield YoKids 酸奶
foodaily
2017.05.04
2017-02-24T00:00:00Z2017-02-24T17:57:37Z来自厄瓜多尔的零食公司Terrafertil Natures Heart收购了加利福尼亚本土的超级食品公司Essential Living Foods,标志着这家全球化公司进军美国市场的第一步。Terrafertil是
foodaily
2017.05.04
珍珠奶茶是从台湾起源的;快乐柠檬、Coco奶茶、一点点是台湾企业开在大陆的连锁品牌;在过去的20年里,台湾茶饮超过大陆的不止一个段位。今天我们就来研究一下台湾当下最热的茶饮趋势,从这位前辈身上取取经。1当星巴
咖门
2017.05.03